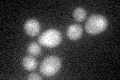
YMR181C

View description
Protein of unknown function; mRNA transcribed as part of a bicistronic transcript with a predicted transcriptional repressor RGM1/YMR182C; mRNA is destroyed by nonsense-mediated decay (NMD); YMR181C is not an essential gene
Localization:
Intensity:
Fold change:
Significance:
-
C’ GFP library in SD

below threshold19.84 -
N' NOP1pr-GFP in SD

cytosol50.0104 -
N' TEF2pr-mCherry in SD

below threshold8.79019 -
N' NATIVEpr-GFP in SD

ambiguous18.6995 -
N' TEF2pr-VC and Cyto-VN in SD

below threshold22.9123 -
C’ GFP library in SD+DTT
cytosol19.320.97No -
C’ GFP library in SD+H2O2

cytosol17.410.87No -
C’ GFP library in Starvation Media

cytosol18.340.92No -
C’ GFP library on the background of Pup2-DaMP

below threshold -
C’ GFP library on the background of CCT mutant

below threshold17.19150.866368No
